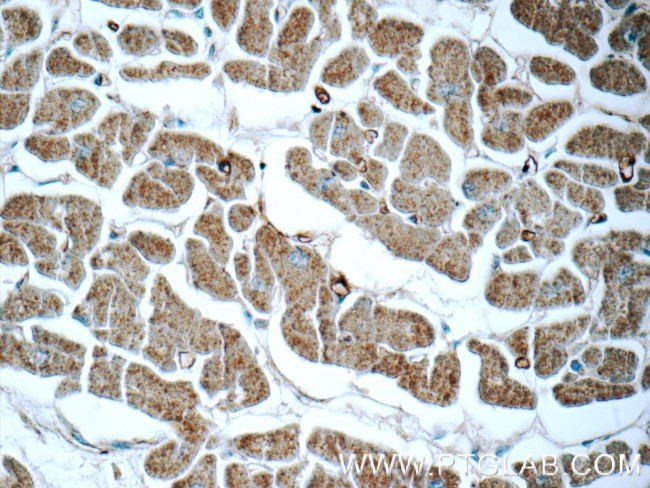
APCDD1 Antibody in Immunohistochemistry (Paraffin) (IHC (P))

Search
Proteintech
APCDD1 Polyclonal Antibody
{{$productOrderCtrl.translations['antibody.pdp.commerceCard.promotion.promotions']}}
{{$productOrderCtrl.translations['antibody.pdp.commerceCard.promotion.viewpromo']}}
{{$productOrderCtrl.translations['antibody.pdp.commerceCard.promotion.promocode']}}: {{promo.promoCode}} {{promo.promoTitle}} {{promo.promoDescription}}. {{$productOrderCtrl.translations['antibody.pdp.commerceCard.promotion.learnmore']}}
产品信息
17024-1-AP
种属反应
宿主/亚型
分类
类型
抗原
偶联物
形式
浓度
规格
纯化类型
保存液
内含物
保存条件
运输条件
产品详细信息
Immunogen sequence: TEADYQLHNV QVICHTEAVA EKLGQQVNRT CPGFLADGGP WVQDVAYDLW REENGCECTK AVNFAMHELQ LIRVEKQYLH HNLDHLVEEL FLGDIHTDAT QRMFYRPSSY QPPLQNAKNH DHACIACRII YRSDEHHPPI LPPKADLTIG LHGEWVSQRC EVRPEVLFLT RHFIFHDNNN TWEGHYYHYS DPVCKHPTFS IYARGRYSRG VLSSRVMGGT EFVFKVNHMK VTPMDAATAS LLNVFNGNEC GAEGSWQVGI QQDVTHTNGC VALGIKLPHT EYEIFKMEQD ARGRYLLFNG QRPSDGSSPD RPEKRATSYQ MPLVQCASSS PRAEDLAEDS GSSLYGRAPG RHTWSL
靶标信息
APCDD1 (Drapc1) is a novel protein that has been shown to be a target of Wnt/beta-catenin signaling pathway in cancer cell lines. APCDD1 is overexpressed in colorectal carcinogenesis and is deregulated in CTNNB1-mutated Wilms tumors.
仅用于科研。不用于诊断过程。未经明确授权不得转售。
篇参考文献 (0)
生物信息学
蛋白别名: Adenomatosis polyposis coli down-regulated 1 protein; Adenomatosis polyposis coli down-regulated 1 protein homolog; apcdd1; APCDD1 (HGNC:15718); ethanol induced gene product EIG180; hypoptrichosis simplex; Protein APCDD1; unnamed protein product
基因别名: AB023957; APCDD1; AU041258; B7323; DRAPC1; EIG180; FP7019; HHS; HTS; HYPT1
UniProt ID: (Human) Q8J025, (Mouse) Q3U128
Entrez Gene ID: (Human) 147495, (Mouse) 494504